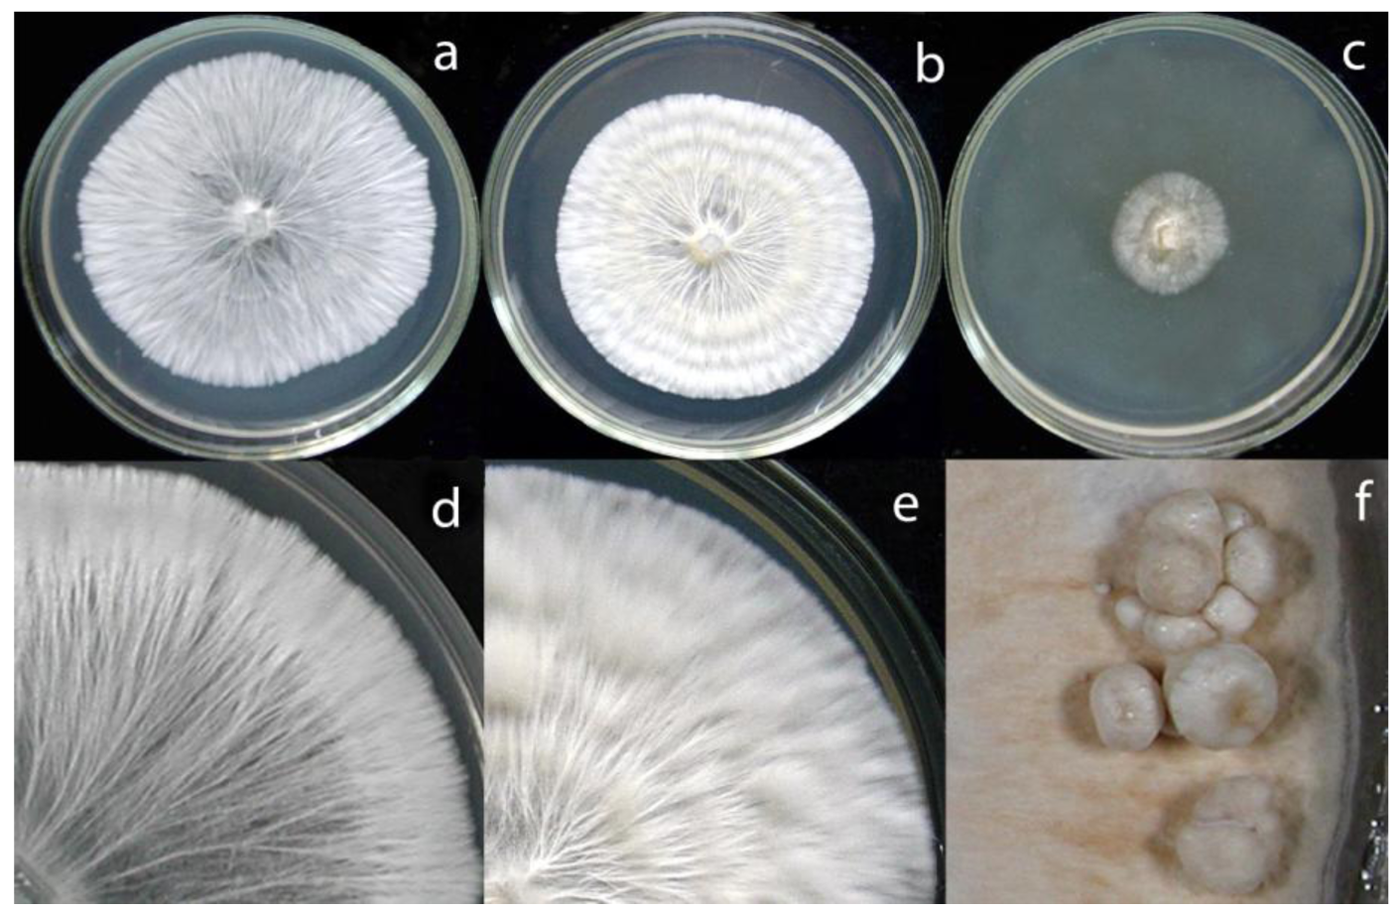
Diversity 03 00136f5 1024
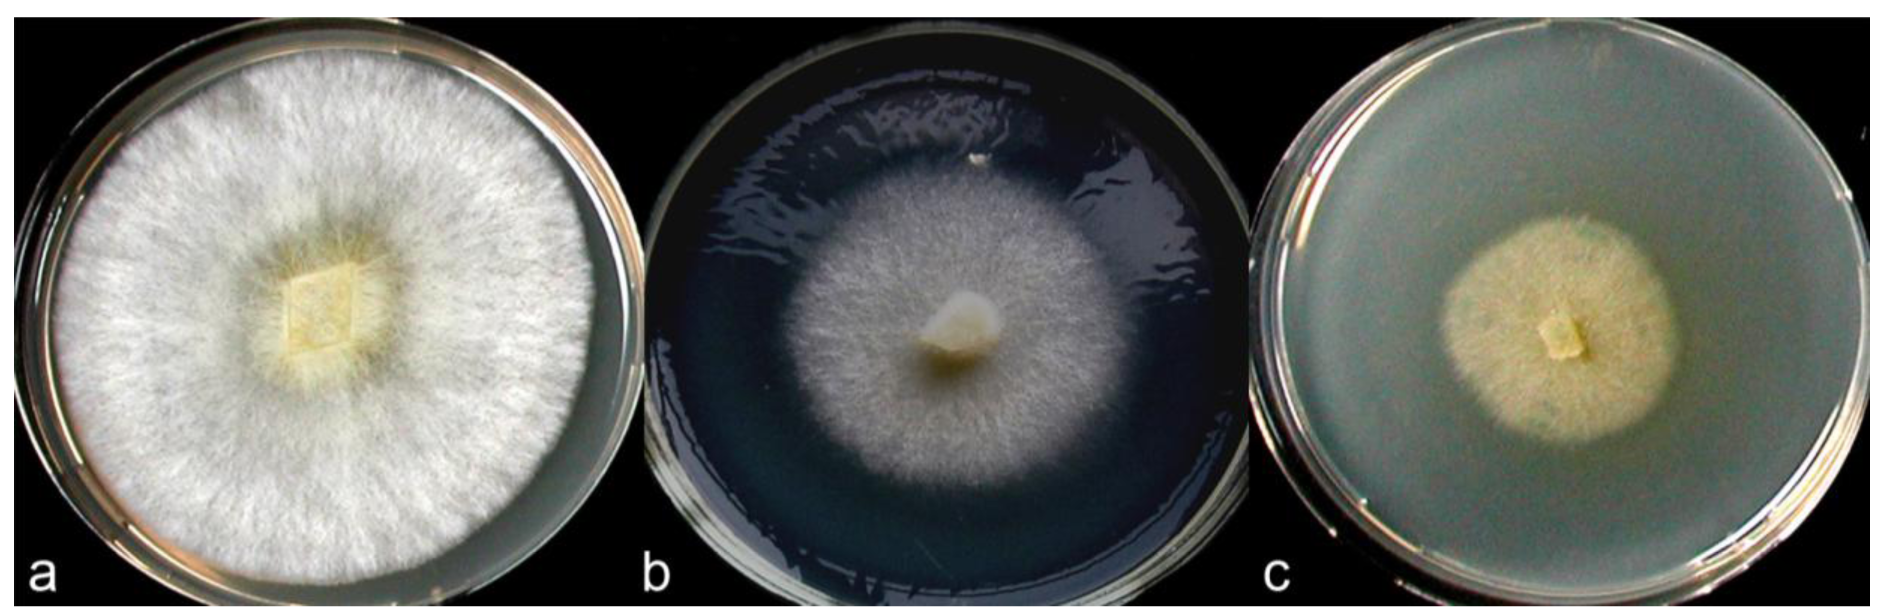
Diversity 03 00136f7 1024
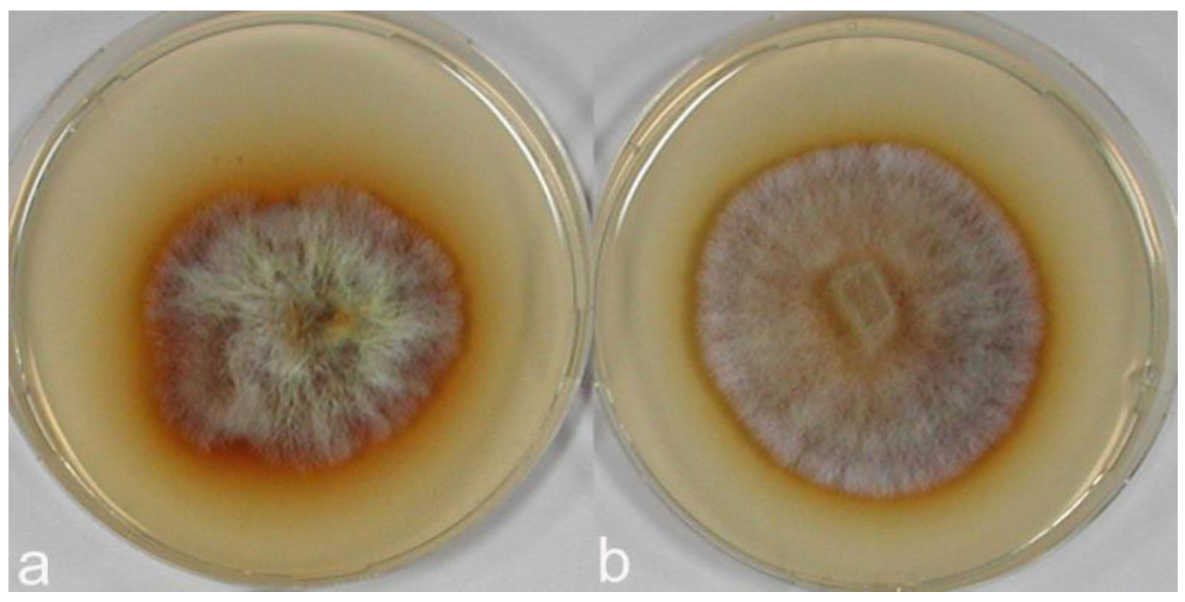
Diversity 03 00136f9 1024

New Armenian Wood-Associated Coprinoid Mushrooms: Coprinopsis strossmayeri and Coprinellus aff. radians
Abstract
: Coprinoid mushrooms grown on wood of broad-leaf species were collected for the first time in Armenia and dikaryotic mycelial cultures were established. ITS (internal transcribed spacer) sequences identified one species as Coprinopsis strossmayeri and the other as a species closely related to Coprinellus radians. Mycelial growth and morphological features on different media are described. The pearl-white-silky colonies of C. strossmayeri are characterized by mycelial strands and by a light-yellow agar colorization. The species forms chlamydospores intercalary in its hyphae. Some hyphal ends form hyphal loops. Colonies of C. aff. radians have a characteristic yellow pigmentation and stain the agar yellowish. Hyphae are mostly clampless but at some septa, pseudoclamps are seen from which side-branches develop growing along the parental hyphae. In the mycelium of C. aff. radians, hyphal loops, hyphal swellings, cystidia and typical allocysts were observed. Both new species from Armenia show growth optima at temperatures of 25 to 30 °C and pHs of 6.0 to 7.0. Both grow in alkaline conditions up to pH 12.0 but not at pHs 3.0 and 4.0, classifying them with other coprinoid mushrooms as “ammonia fungi”. Both species grew on a variety of lignocellulosic substrates and both show polyphenol oxidase activities.1. Introduction
Modern molecular data recently lead to a drastic change in nomenclature in the kingdom of fungi with definitions of new phyla, classes and orders. The phylum Basidiomycota from the subkingdom Dikarya has now been split in eleven different classes, of which the subclass Agaricomycetidae in the class Agaricomycetes corresponds largely to the classical Homobasidiomycetes plus the Auriculariales and Sebacinales. The Agaricomycetidae consists of three orders, one of which is formed by the Agaricales, equivalent to the Euagarics clade [1]. Clades and families within the Agaricales have also been reorganized with currently some provisional names as further analysis is expected to cause more classification and name changes [2,3]. The genus Coprinus Pers. (Coprini or coprinoid mushrooms) with around 200 species within the traditional family Coprinaceae of the Agaricales was shown not to be monophyletic. This genus was therefore subdivided into four new clades (genera): Coprinus s. str. now grouped in the family of Agaricaceae, and Coprinopsis P. Karst., Coprinellus P. Karst. and Parasola gen. nov. grouped in the new family of Psathyrellaceae [4,5].
Coprinoid mushrooms have a large distribution in Armenia (Figure 1; [6]). In total, eighteen species have already been described in the literature [7-11]. Sixteen of them belong to reclassified species from the above mentioned genera [5]: Coprinus comatus and Coprinus sterquilinus from the family of Agaricaceae and Coprinopsis atramentaria (Coprinus atramentarius), Coprinopsis cinerea (Coprinus cinereus), Coprinopsis extinctoria (Coprinus extinctorius), Coprinopsis lagopus (Coprinus lagopus), Coprinopsis nivea (Coprinus niveus), Coprinopsis picacea (Coprinus picaceus), Coprinellus congregatus (Coprinus congregatus), Coprinellus disseminatus (Coprinus disseminatus), Coprinellus domesticus (Coprinus domesticus), Coprinellus impatiens (Coprinus impatiens), Coprinellus micaceus (Coprinus micaceus), Coprinellus truncorum (Coprinus truncorum) and Parasola plicatilis (Coprinus plicatilis) from the family of Psathyrallaceae (former names are given in brackets). Two of the species documented in Armenia, Coprinus aphthosus and Coprinus silvaticus, have not yet been reclassified.
The majority of coprinoid mushrooms are fimicolous and occur on herbivore dung and soil [12]. However, about 40% of all species have also been found on trees and/or on solid or decaying wood, suggesting that a wood-degrading ability (xylotrophy) might be more widespread among these fungi than assumed so far [13,14]. Among the Armenian Coprini reported to date, at least fifteen species (C. atramentaria, C. aphthosus, C. comatus, C. congregatus, C. cinerea, C. disseminatus, C. domesticus, C. extinctoria, C. impatiens, C. lagopus, C. micaceus, C. picacea, C. truncorum, C. silvaticus and P. plicatilis) have the ability to associate with wood [14].
In this paper, we describe two new coprinoid species [Coprinopsis strossmayeri (Coprinus strossmayeri) and Coprinellus aff. radians (Coprinus radians)] for Armenia (Figure 1) with fruiting bodies found on wooden material. Morphological and physiological growth characteristics of mycelia and nuclear ribosomal ITS (internal transcribed spacer) and 28S rRNA sequences for molecular identification are reported.
2. Material and Methods
2.1. Fungal Material and Culture Conditions
Fruiting bodies of one species were first collected on an ash tree stump (Fraxinus sp.) in the town centre of Yerevan (Charentc St.; mushroom group 15/species 1) in May 2002 [15] and again in June 2005 in a Yerevan city park (Saryan Square; mushroom group 1/species 1) on leaf and woody coarse litter of Platanus orientalis. Fruiting bodies of the second species (mushroom group 1/species 2) were found on a woody fence in north-western Armenia in the park of the city Gyumri (Shirakatci St.) in June 2002 [15]. Fourteen dikaryotic mycelia were isolated from tissues of caps (C samples) and stipes (S samples) of the collected fruiting bodies or obtained from dense plating of basidiospores (PS samples), using malt-extract agar (MEA; 1.5% malt-extract, Oxoid, Basingstoke, England; 1.5% agar, Serva, Heidelberg, Germany) with chloramphenicol (100 mg/L). Isolates were labeled by the group of mushrooms collected, the number of the mushroom within a group and the type of culture isolation, i.e., isolates from nine different fruiting bodies of the first species were 15-1S, 15-1C, 15-2C, 15-3C, 1-1S, 1-2S, 1-3S, 1-4S, 1-5C, 1-5S, 1-6C, and 1-6S, and strains isolated from two different fruiting bodies of the second species were 1-2PS and 1-1C, respectively. Strains were incorporated into the Culture Collection of the Laboratory of Fungal Biology and Biotechnology (FBBL), Yerevan State University under the catalogue numbers 1060–1062, 1064, 1066–1073, 1036 and 1037, following the order of strains as given above [16].
For further characterization, cultures were inoculated onto different agar media with a pH adjusted to 6.0 in Ø 90 mm Petri dishes: 1.5% MEA, potato-dextrose agar (PDA; 3.9% potato-dextrose agar, Difco, Detroit, USA) and glucose-peptone agar (GPA; 4.0% glucose, Merck, Darmstadt, Germany; 1.0% peptone, Difco, Detroit, USA; 1.5% agar, Serva, Heidelberg, Germany). Macromorphological characteristics and textures of colonies and growth parameters of mycelia were analyzed after an incubation period of seven days in darkness at 25 °C (three cultures per isolate), making use of Nobles's and Stalpers's scales [17,18]. Forms, densities and pigmentations of mycelia and pigmentations within the agar were recorded. Average radial growth rates (GR) of mycelial colonies were determined by the formula GR (mm/d) = (rn− r2)/(tn− t2) where r2 and rn were the radii of the colonies (in mm) on the second (t2) and seventh (tn) day of growth, respectively. Effects of pHs (pH 3.0 to pH 12.0 with 1 unit increment at 25 °C) and temperatures (5, 15, 20, 25, 30, and 37 °C at pH 6.0) on growth on MEA were tested. Average diameters of colonies were determined on days seven and 10 and respective growth rates (mm/d) calculated. Fruiting abilities of isolates were tested on MEA and PDA media at 25 °C under a defined 12 h light/12 h dark regime with specific light energy parameters as established for fruiting of C. cinerea [19] or under a normal day/night regime at room temperature (RT) in the laboratory.
For investigation of micromorphological characteristics, sterile microscope cover slips (2 × 2 cm) were placed onto MEA plates next to growing mycelia and plates were further incubated at 25 °C [20]. Once mycelia overgrew the cover slips, these were removed together with the mycelia for examination under an Axioplan-2 imaging microscope (Zeiss, Goettingen, Germany) after staining with a 0.1% methylene-blue aqueous solution. Photos were taken with a Colour View II Mega Pixel digital camera for picture imaging using analySIS® software (Soft Imaging System, Münster, Germany).
2.2. Genetic Identification of Culture Collections
Isolates of species 1 (15-1S, 15-2C, 15-3C) and species 2 (1-2PS) were grown in liquid 1.5% malt-extract medium in Ø 90 mm Petri dishes at 25 °C. Genomic DNA was isolated from harvested and lyophilized mycelium following the protocol of Pukkila and Zolan [21]. PCR was performed with 200 ng genomic DNA and primers o18S.1760 (5′-CCGTCGCTACTACCGATTG-3′) and o28S.340r (5′-GTCTCTCGCCAATATTTAGCTTTAG-3′) designed in this work from fungal 18S rRNA and 28S rRNA genes, respectively, and 4 U Taq polymerase (Qiagen, Hilden, Germany) in a volume of 50 μ L. Reaction conditions were 60 s 93 °C, followed by 32 cycles of 40 s 93 °C, 40 s 53 °C, and 120 s 70 °C. Alternatively, PCR reactions were performed with 5 ng DNA, ITS1 (5′-TCCGTAGGTGAACC- TGCGG-3′) and primer ITS4 (5′-TCCTCCGCTTATTGATATGC-3′) and 1 U Taq polymerase in a volume of 20 μ L as described by Naumann et al. [22]. DNA was recovered from the reaction using the MinElute system (Qiagen, Hilden, Germany) and cycle sequenced using Big Dye Terminators (Applied Biosystems, Darmstadt, Germany) and primers o6S.40 (5′-GATGAAGAACGCAGCGAAATG-3′), o6S.114r (5′-GTGCGTTCAAAGATTCGATGATTC-3′), o28S.40 (5′-GCATATCAATAAGCGGAG- GAAAAG-3′) and o28S.60r (5′-CTTTTCCTCCGCTTATTGATATGC-3′) in addition to the primers o18S.1760 and o28S.340r. The sequence data were collected using an ABI377 sequencer (Applied Biosystems, Darmstadt, Germany). The data were processed with the PHRED program [23], assembled and manually verified on trace data level with the GAP4 software [24]. Sequence similarity to the rDNA-ITS range of reference strains was detected by blastn against the NCBI GenBank database ( http://www.ncbi.nlm.nih.gov/BLAST/). Identity values were taken either from the blastn results or from alignments performed by the NCBI tool for blasting two sequences bl2seq. Own sequences and multiple reference sequences from the database were aligned using ClustalX ( http://www-igbmc.u-strasbg.fr/BioInfo/ClustalX/Top.html) and GeneDoc version 2.6.2002 ( http://www.psc.edu/biomed/genedoc/). Following manual adjustments, phylogenetic trees of the nucleotide sequence alignments were calculated by the neighbor joining method of the program MEGA, version 4.0 [25].
2.3. Detection of Extracellular Polyphenol Oxidase Activities and Growth on Lignocellulosic Substrates
Activity of putative extracellular oxidoreductases acting on polyphenols (polyphenol oxidases) was tested at 25 °C on MEA supplemented with either 0.5 g/L gallic acid or with 0.5 g/L tannic acid (Bavendamm test) [26]. Colony diameters of strains inoculated on MEA were recorded on day 7 of growth and growth values (mm/d) calculated. Pigmentation of agar and mycelium was scaled. Presence of potential laccases secreted by established mycelium was tested using syringaldazine (0.1% solution in 95% ethanol), α-naphthol and guaiacol (0.1 M solutions in 95% ethanol) as reagents. Drops of the solutions were spotted onto mycelium and streaked radially away from the colony well beyond the margin of the mycelium. Respective color reactions (pink-violet, blue and orange-gold) were recorded after 15 min and 1 hour of incubation, using a scale of intensity from 0 to 6 [27,28].
Abilities of strains to grow on lignocellulose substrates were studied on Populus sp. and Fagus sylvatica sawdust, Triticum aestivum straw, and leaf litter from Quercus robur and from Acer platanoides. Substrates were chopped and dried overnight at 104 °C. Per growth test, 10 g of a given substrate were filled into 500 mL Erlenmeyer flasks and supplemented with 30 mL water before autoclaving. Ten plugs of a fungal culture grown on MEA at 25 °C were transferred into a flask (three replicates per substrate and strain) for incubation for at least three months at 28 °C. General development of the cultures was periodically observed. In case needed, additional water was provided in 10 mL sterile aliquots. Potential laccase activities were semi-quantitatively determined at the end of the cultivation period. Aliquots of approximately 0.5 cm3 of mycelium-covered substrate were transferred into 1.5 mL Eppendorf tubes with 1 mL of 120 mM sodium acetate buffer, pH 5.6 and 100 μL of the laccase substrate ABTS [2,2′-azino-bis(3-ethylbenzothiazole-6-sulfonic acid); 50 mM] added [29]. The samples were incubated for 10 min at RT. A green-blue coloration of the solution caused by an oxidation of the uncolored ABTS indicated potential laccase activity.
3. Results
3.1. Fungal Collections and Strain Isolations
Fruiting bodies of a coprinoid species grown in a small group in May 2002 (collection 15) on an ash tree stump in Yerevan were about 8 to 12 cm in length with a stipe width of 7 to 8 mm. The about 2.5 to 3 cm long caps of the mature and already autolyzing fruiting bodies were not fully open (not shown). The caps were covered by small felty whitish to yellowish scales representing rests of a veil. Stipes were whitish with their lower thirds being scattered with velar remnants. Inside, stipes were light brownish and hollow. The dark red-brown spores were ovoid, 8–9 × 5–6 μm in size and had a rounded apex and a pointy central germ pore (Figure 2b). All morphological characteristics fit with fruiting bodies of the species C. strossmayeri [30,31]. In June 2005, the species was found again in tufts of fruiting bodies (collection 1) on leaf and woody coarse litter of P. orientalis in a city park in Yerevan (Figure 2a,c). From fruiting bodies of both collections, mycelial cultures were generated (see list of isolates in the Material and Methods section).
The second coprinoid species found in 2002 on a woody fence in the city of Gyumri, grew in a small group of fragile, 6 to 8 cm tall mushrooms. Since being already in the state of autolysis, a morphological description of the fruiting bodies cannot be given. Mycelial remnants of the autolyzing mushrooms and spores were used to generate two mycelial cultures from two fruiting bodies (1-1 and 1-2) of this species (strains 1-1C and 1-2PS).
3.2. Genetic Identification of Mycelial Isolates
Mycelial cultures of isolates 15-1S, 15-2C, 15-3C (from different fruiting bodies of species 1) and 1-2PS (species 2) were used for species identification through molecular data from nuclear ribosomal DNA-ITS sequencing. For 15-2C, we sequenced the ITS1-5.8S-ITS2 regions together with 250 bp upstream region of the 28S rRNA gene. Sequences obtained for strains 15-1S and 15-3C were identical in overlapping regions to the 15-2C sequence, indicating that the three strains come from the same species and possibly from one individual that produced the different mushrooms in 2002. From isolate 1-2PS, we obtained additional 2,500 bp sequence of the 28S rRNA gene. Sequences were deposited in NCBI GenBank under accession numbers FJ403470, FJ185161, FJ403472 and FJ185160, respectively.
Using the complete ITS1-5.8S-ITS2 sequence of isolate 15-2C, blastn searches against the GenBank database revealed highest similarity (98%; compare Figure 3) to the ITS1-5.8S-ITS2 sequence entries EU918699 of a strain labeled C. strossmayeri and AB071797 of a strain labeled Coprinus rhizophorus (= C. strossmayeri) [32,33]. When taking the 250 bp-long partial sequence of the 28S rRNA gene, the closest sequences in the NCBI database were the C. strossmayeri entry EU621791 (98% identity) and the entry AF139945 (98% identity) from a strain identified as Coprinus quadrifidus (= Coprinopsis variegata [5]). The latter entry also contains the 5.8S rRNA gene sequence and that of spacer ITS2 while the ITS1 sequence is not available. When taking just the 389 bp including the 5.8S-ITS2 fragment from our strain 15-2C, the best hit was AB071797 (98% identity, gaps 3/389) and the second best was AF139945 (97% identity, gaps 7/389) suggesting that our isolate is more closely related to the first strain, i.e., C. strossmayeri. Although the two species are closely related (the 5.8S-ITS2 sequences are 96% identical) and, moreover, occur in similar ecological conditions [30,34], they are morphologically distinct. C. variegata is a North American species with up to 12 cm-long mushrooms growing also in groups on decaying hardwoods. However, it can easily be distinguished from the European-Asian C. strossmayeri by the larger, loose, whitish to tan scales, and patches that cover the caps of its mushrooms and by the partial veil remnants attached in ring form to the mushroom stipes [30,34]. Thus, the morphological features of our species and the high sequence identity to NCBI database entries EU621791 and AB071797 suggest our isolates from Yerevan to be C. strossmayeri.
The ITS1-5.8S-ITS2 sequence of strain 1-2PS from the second species hit in blastn searches various sequences assigned to species of the genus Coprinellus. The sequence with highest similarity was AY461815 from a Coprinellus radians strain (98% identity). Other top-scoring blastn hits gave identities of 95–97%. When analyzing the similarity of the ribosomal RNA gene cluster sequences of the top-scoring blastn hits more thoroughly in a multiple alignment, the sequence of strain 1-2PS grouped ambiguously well to entries of C. radians and C. xanthothrix and slightly less well to entries of C. curtus, C. disseminatus, C. flocculosus, C. micaceus, and C. verrucispermus (Figure 3), which are all closely related members of the genus Coprinellus [4,5]. Another group of closely related sequences came from unidentified fungal species that were isolated as mycorrhizal fungi associated with the achlorophyllous orchid Epipogium roseum [35]. Of these, the basidiomycete KA3-2 (AB176577) was most identical to strain 1-2PS (97% identity). Another closely related sequence is AM901964 (97% identity) amplified from an uncultured basidiomycete present in an indoor dust fungal flora [36].
Looking closer at the alignment of the ITS1-5.8S-ITS2 sequences (Figure 4), we deduce that our strain quite likely represents another closely related species to C. radians and the mycorrhizal fungus KA3-2. We therefore refer to the species as Coprinellus aff. radians. The extra 2,500 bp from its 28S rRNA gene in blastn searches did not help in further solving the species affiliation. The first 1,076 bp of the gene hits with 98–99% identity partial sequences of the 28S rRNA genes from a C. micaceus strain (AY207182), a C. disseminatus strain (AY207180) and a C. xanthothrix strain (AY207193) supporting the affiliation of the strain 1-2PS to the genus Coprinellus. For the remaining 28S rRNA gene sequence, sequences from other Coprinellus species are still lacking in GenBank.
3.3. Mycelial Morphology and Growth Parameters of Coprinopsis strossmayeri Strains
According to Nobles's and Stalpers's scales [17,18], colonies of the C. strossmayeri isolates obtained from the two different collections in Armenia can be described as pearl-white-silky on all tested media (Figure 5). As documented in Figure 5a–c, at 25 °C and pH 6.0 mycelia of the different C. strossmayeri strains were fast growing on MEA (GRs were from 5.3 to 7.2 mm/d) and PDA (GRs were from 4.3 to 5.3 mm/d). In contrast, on GPA colonies developed only poorly (GRs were from 1.2 to 1.9 mm/d). Tested on MEA (pH 6.0), the strains propagated at a wide range of temperatures (15–37 °C) with a temperature optimum at 25–30 °C. On MEA at 25 °C, the strains grew from pH 5.0 to pH 12.0 with an optimum at pH 6.0 to 7.0. Colony growth at weak alkaline conditions (pH 8.0 and pH 9.0) was relatively good (average GRs were 3.8 and 3.7 mm/d, respectively). Strains did not grow at pH 3.0 and pH 4.0 and at a temperature of 5 °C.
Depending on media composition, morphological variations of colonies were observed. On MEA at 25 °C and pH 6.0, colonies were characterized by prominent radial cords and little fluffy aerial mycelium (Figure 5a,d). On PDA at 25 °C and pH 6.0, mycelia formed dense colonies with radial-parallel mycelial cords within well developed fluffy aerial mycelium growing in undulating concentric zones (Figure 5b,e). On both MEA and PDA, the mycelium was initially pearl-white. In aging PDA colonies, the concentric growth zones stained brownish whereas in aging MEA colonies radial strands turned beige-brown (not shown). In both cases over time, the agar was light-yellow pigmented. Primordia were observed on MEA in aging cultures kept at RT in a day-night regime (Figure 5f) but fruiting body development did not complete. Fruiting body primordia were however not observed at 25 °C under a defined 12 h light/12 h dark regime. Moreover, sclerotia were not formed in the colonies under any of the culture conditions tested in this study. However, cultures of C. strossmayeri had a strong fungal smell on all tested media.
Hyphae of the C. strossmayeri strains were intensively vacuolated and granulated on PDA and MEA media (Figure 6a,b). Intense vacuolization occurred at a young hyphal age already in 3 d-old cultures. Also at this early age, chlamydospores formed intercalary upon localized hyphal swelling (Figure 6c,d). Single, round, arch-shaped clamps were often seen at the hyphal septa of the dikaryotic strains (Figure 6e–l) and septa without clamp cells could also be observed (Figure 6h). Moreover, hyphal loops were occasionally seen within the mycelium (Figure 6m) whereas asexual spores in the aerial mycelium were not detected.
3.4. Mycelial Morphology and Growth Parameters of Coprinellus aff. radians Strains
At 25 °C and pH 6.0, C. aff. radians strains grew best on MEA (GRs were from 5.4 to 6.4 mm/d) compared to PDA (GRs were from 4.8 to 5.2 mm/d) and GPA (GRs were 2.4 to 3.2 mm/d), (see Figure 7). On MEA at pH 6.0, growth occurred over a wide range of temperatures (15–37 °C) with an optimum at 25–30 °C. Strains did not grow at 5 °C. On MEA at 25 °C, strains grew from pH 5.0 to pH 12.0 with an optimum at pH 7.0. Growth was good at weak acidic (pH 6.0) to weak alkaline conditions (pH 8.0–9.0). There was no mycelial growth at pHs 3.0 and 4.0.
Colonies of C. aff. radians on MEA, pH 6.0 at 25 °C, were initially white with well developed fluffy aerial mycelium (Figure 7a) that over time became more dense and turned dark yellow. At the same time, the agar also turned yellowish. On PDA, pH 6.0 at 25 °C, the colonies grew less dense with little aerial mycelium (Figure 7b). Initially, the mycelium was white but the growing colonies also turned yellow over time, starting from the inoculum. On GPA, pH 6.0 at 25 °C, growth at the substrate surface was more compact but there was little aerial mycelium. Also on GPA, the colonies stained yellow already during growth (Figure 7c). Primordia, fruiting bodies and sclerotia did not develop in any of our cultures, also not when strains were cultivated under a specific light/dark regime at 25 °C or when they were stored in the laboratory at RT under the normal day/night rhythm.
The mycelium of C. aff. radians strains consisted of parallel growing, mostly clampless hyphae (Figure 8a,b). Rare pseudoclamps were detected (Figure 8c–e), regardless of whether a dikaryotic strain was isolated from mycelial cap tissue (strain 1-1C) or by dense plating of basidiospores (strain 1-2PS). Side branches appeared to develop from such pseudoclamps in order to grow parallel to the parental hyphae (Figure 8a,b). Within the mycelium, hyphal swellings (Figure 8f–h) and allocysts of different ages (Figure 8i–r) were repeatedly found in the C. aff. radians colonies. The allocysts present swollen terminal cells with dense cytoplasm and were already described for C. radians by Clémençon [37]. Other types of spores or duration structures were not observed in the mycelium of C. aff. radians but hyphal loops (Figure 8s–u) and mycelial cystidia (Figure 8v) were often formed.
3.5. Polyphenol Oxidase Activities of Coprinopsis strossmayeri and Coprinellus aff. radians Strains and Growth on Lignocellulosic Substrates
In polyphenol oxidase tests on MEA medium with gallic and tannic acids performed with C. strossmayeri strains 15-2C and 15-3C and C. aff. radians strains 1-2PS and 1-1C, enzymatic activities were detected in all cultures of both species. Based on the intensities of agar staining, strains of C. strossmayeri showed moderate activities on MEA with gallic acid and weak activities on MEA with tannic acid (not shown), while the polyphenol oxidase activities of the C. aff. radians strains were strong with gallic acid (Figure 9) and moderate with tannic acid (not shown). Notably, gallic and tannic acids negatively affected growth of C. strossmayeri (average GRs were 1.5 and 2.1 mm/d, respectively) and growth of C. aff. radians (average GRs were 2.7 and 3.5 mm/d, respectively).
All the C. strossmayeri strains reacted weakly with syringaldazine and strongly with α-naphthol and guaiacol (not shown). Reactions of C aff. radians were strong with all three reagents, particularly with α-naphthol (not shown).
Growth of C. strossmayeri isolates 15-1S, 15-2C and 15-3C and of C. aff. radians 1-2PS was tested on various lignocellulosic substrates (sawdust of Populus sp. and of F. sylvatica, T. aestivum straw, Q. robur leaves and A. platanoides leaves).
The C. strossmayeri strains grew well on most substrates, except C. strossmayeri strain 15-1S that grew only well on wheat straw. Other isolates grew best on wheat straw, then on the two types of sawdust (Figure 10a,b) and least on the leaf litters. At the end of the cultivation, strain 15-2C showed apparent laccase activity on wheat straw and on the two types of sawdust and strain 15-3C showed laccase activity on wheat straw.
C. aff. radians strain 1-2PS grew on all tested lignocellulosic substrates. Growth was especially good on wheat straw and moderately on the leaf litter substrates (Figure 10c,d) although a strong enzymatic activity with ABTS was detected on the leaf litters and a comparably weak activity on wheat straw.
4. Discussion
Two new coprinoid species for Armenia are described in this study. Due to the fast autolysis of the mushrooms, we could only analyze the morphology of fruiting bodies for one species. Features of fruiting bodies and basidiospores suggested this species to be C. strossmayeri. This species was originally described in 1879 under the name Coprinus strossmayeri S. Schulz and, subsequently, under the synonymous names Coprinus rhizophorus Kawam, C. rhizophorus A. Kawam ex Hongo & K. Yokoyama, Coprinus populicola Mornand, nov. sp., and Coprinus tomentosus Fr. sensu Moser prior to the currently valid classification as Coprinopsis strossmayeri [5,31]. Sequencing the ITS region of mycelial isolates from our collections from Armenia supported the morphological classification of the species to C. strossmayeri (Figure 3). Sequences from C. strossmayeri and C. rhizophorus with 98% identity to our sequences are available in the NCBI database.
C. strossmayeri has previously been observed in Japan on decayed wood in a Cryptomeria japonica plantation [38]. Although the species is rare in Europe [31,39,40], tufts of fruiting bodies have repeatedly been observed on wood or wood remnants of broad-leaf trees, mostly in the months May to July [31-33,41,42]. With the discovery of C. strossmayeri in Armenia, the worldwide known localities of the species has risen to fourteen different places and twelve different countries (this study; [15,31,38-40]). Our Armenian collections were taken in May 2002 and in June 2005 from fruiting body clusters occurring on wood of the broad-leaf trees F. excelsior and P. orientalis, respectively. In general, little is known on growth of coprinoid species on wood and on their potential of wood degradation. The sparse data available from the literature suggest that some coprinoid species may cause white-rot [13,14,43]. Substrate tests performed in this study indicate that strains of C. strossmayeri can grow reasonably well on wheat straw and on sawdust from certain broad-leaf species and moderately also on leaf litter material. Polyphenol oxidase activities as required for lignin degradation by white-rot fungi [44,45] were detected in growth tests on agar supplemented with either gallic or tannic acids (Bavendamm tests) and by snap-shot laccase tests of mycelial samples from cultures grown on lignocellulosic material. Future work will need to more thoroughly address the question of enzyme production and the ability of decay of lignocellulosic substrates by C. strossmayeri.
In accordance with the low nitrogen conditions in lignocellulosic substrates [46,47], C. strossmayeri does not favor media of high nitrogen content for growth. Strains grow well on malt extract and potato dextrose but not on artificial medium rich in glucose and high in nitrogen such as GPA (see Results). We used growth on artificial medium in order to describe colony and hyphal growth and their morphologies. In the future, these data may help to identify the species by morphological means of colonies when fruiting bodies are not available. To our knowledge, hyphal and colony morphologies are described for the first time for this species. Prominent morphological features are the strands in the colonies (Figure 5d), the young intensively vacuolated and granulated hyphae (Figure 6a,b) with single, arch-shaped clamp cells (Figure 6e–l). Formation of thick-walled colorless chlamydospores, whose cytoplasm is easily stained by 1% methylene-blue (Figure 6c,d), is another obvious characteristic of C. strossmayeri colonies.
C. radians is a wide-spread species in Europe with fruiting bodies found in groups or solitary around trunks, branches or on logs of deciduous trees [30]. The species has white-rotting abilities on pre-decayed wood [43]. ITS sequencing suggests our second species sampled from a wooden fence in Armenia to be very closely related to C. radians (Figures 3 and 4) but due to the lack of further molecular data in the sequence databases, we currently cannot define the species further. However, we describe morphological features of growing colonies that possibly define the species quite well: regardless of the medium used, colonies have a yellow color due to strong pigmentation. Hyphae frequently show parallelized growth, branching is rare (Figure 8a,b) and tends to be an outgrowth of pseudoclamps (Figure 8c–e). In this connection it is interesting to note that in C. radians, pseudoclamps are described in the mushrooms but no fused clamps [30,32]. Another specific feature of the Armenian C. aff radians strains shared with C. radians, is the formation of allocysts (Figure 8i–r). Allocysts of C. aff. radians and C. radians are of identical appearance [36]. Hyphal swellings (Figure 8f–h), loops (Figure 2s–u) and cystidia (Figure 8v) are further hyphal differentiations that can be observed in the mycelia of the Armenian C. aff. radians strains.
The C. aff. radians strains isolated in this study showed polyphenol oxidase activities in all tests performed, including on lignocellulosic substrates, in accordance to a potential wood decaying activity. A recent paper describes that the alkalitolerant C. radians does not produce classic ligninolytic peroxidases active at acidic pHs (pH 2.5 to 5.5) but a new type of haloperoxygenase being active also at alkaline pHs with typical peroxidase and laccase substrates [48]. The specific nature of the enzymatic activities in our strains will have to be addressed in the future. In the literature, C. radians, Coprinopsis phlyctidospora, Coprinopsis echinospora, Coprinopsis neolagopus and C. cinerea are described to grow at alkaline pHs [14,28]. Soponsathien coined the name “ammonia fungi” for species growing at such pHs [28]. “Ammonia fungi” are defined as a chemoecological group of fungi that sequentially develop reproductive structures exclusively or relatively abundantly on soil after a sudden addition of ammonia or other nitrogenous materials that react as bases by themselves or on their decomposition [49]. In this study, increase in colony growth at pH 6.0 to 9.0 was relatively good for both new Armenian species and both species were able to grow up to pH 12.0, allowing us to classify also the C. aff. radians and the C. strossmayeri strains as “ammonia fungi” in agreement to other coprinoid species. Both species are mesophilic by their preferred growth temperature range of 25 to 30 °C.
5. Conclusions
Two new copriniod species are described for Armenia: C. strossmayeri from the genus Coprinopsis and C. aff. radians from the genus Coprinellus. Both species grow on wood and exhibit polyphenol oxidase activities. Macro- and micromorphological features of mycelial cultures are given, that can be used in species identification.

Acknowledgments
Alexandra Dolynska and Alexander Heine are thanked for excellent technical help. SMB thanks the NATO for financial support (grant #980764) and the DAAD for Visiting Fellowship grants to perform parts of this study in the section Molecular Wood Biotechnology and Technical Mycology at the Büsgen-Institute of the University of Goettingen. ITS sequencing of wood-inhabiting fungi was supported by grant 0330551 through the BMBF (Bundesministerium für Bildung und Forschung, Germany) to UK.
References
- Hibbett, D.S.; Binder, M.; Bischoff, J.F.; Blackwell, M.; Cannon, P.F.; Eriksson, O.E.; Huhndorf, S.; James, T.; Kirk, P.M.; Lücking, R.; et al. A higher-level phylogenetic classification of the fungi. Mycol. Res. 2007, 111, 509–547. [Google Scholar]
- Matheny, P.B.; Curtis, J.M.; Hofstetter, V.; Aime, M.C.; Moncalvo, J.-M.; Ge, Z.W.; Yang, Z.L.; Slot, J.C.; Ammirati, J.F.; Baroni, T.J.; et al. Major clades of Agaricales: a multilocus phylogenetic overview. Mycologia 2006, 98, 982–995. [Google Scholar]
- Matheny, P.B.; Wang, Z.; Binder, M.; Curtis, J.M.; Lim, Y.W.; Nilsson, R.H.; Hughes, K.W.; Hofstetter, V.; Ammirati, J.F.; Schoch, C.L.; et al. Contributions of rpb2 and tef1 to the phylogeny of mushrooms and allies (Basidiomycota, Fungi). Mol. Phylogenet. Evol. 2007, 43, 430–451. [Google Scholar]
- Hopple, J.S.; Vilgalys, R. Phylogenetic relationships in the mushroom genus Coprinus and dark-spored allies based on sequence data from the nuclear gene coding for the large ribosomal subunit RNA: divergent domains, outgroups, and monophyly. Mol. Phylogenet. Evol. 1999, 13, 1–19. [Google Scholar]
- Redhead, S.A.; Vilgalys, R.; Moncalvo, J.-M.; Johnson, J.; Hopple, J.S. Coprinus Pers. and the disposition of Coprinus species s. l. Taxon 2001, 50, 203–241. [Google Scholar]
- Flora of Armenia; Takhtajyan, A.L., Ed.; Acad. Sci. Armenia: Yerevan, Armenia, 1954; Volume 1.
- Melik-Khachatryan, J.H. Mycoflora of Armenia. Vol. 5. Agaricales; Yerevan State University: Yerevan, Armenia, 1980. [Google Scholar]
- Nanagulyan, S.G. Agaricoid Mushrooms of Armenia (Basidiomycetes); Yerevan State University: Yerevan, Armenia, 2008. [Google Scholar]
- Nanagulyan, S.G.; Taslakhchyan, M.G. Macromycetes of Dilijan and Khosrov Preserves of Armenia; Yerevan State University: Yerevan, Armenia, 1992. [Google Scholar]
- Nanagulyan, S.G.; Sirunyan, A.L.; Amiryan, A.A. New for Armenia species of Agaricoid and Gasteroid fungi. Trans. YSU 2003, 1, 111–116. [Google Scholar]
- Gharibyan, N.G.; Badalyan, S.M. Materials to study Armenian macroscopic fungi. Trans. YSU 2001, 169, 119–128. [Google Scholar]
- Orton, P.D.; Watling, R. British Fungus Flora. Agarics and Boleti 2. Coprinaceae Part 1: Coprinus; Her Majesty's Stationary Office: Edinburgh, UK, 1979. [Google Scholar]
- Redhead, S.A.; Ginns, J.H. A reappraisal of Agaric genera associated with brown rots of wood. Trans. Mycol. Soc. Japan 1985, 26, 349–381. [Google Scholar]
- Navarro-González, M. Growth, Fruiting Body Development and Laccase Production of Selected Coprini. PhD thesis, University of Goettingen, Goettingen, Germany, 2008. [Google Scholar]
- Badalyan, S.M.; Avetisyan, H.K.; Navarro-González, M.; Szafranski, K.; Hoegger, P.J.; Kües, U. Two new Coprinus species in Armenia associated with wood: Coprinus strossmayeri (Coprinopsis strossmayeri) and a new species closely related to Coprinus radians (Coprinellus radians). Bot. Res. Asian Russia 2003, 1, 8–9. [Google Scholar]
- Badalyan, S.M.; Garibyan, N.G.; Sakeyan, C.Z. Catalogue of the Fungal Culture Collection of the Yerevan State University; Yerevan State University: Yerevan, Armenia, 2005. [Google Scholar]
- Nobles, M. Identification of cultures of wood-inhabiting Hymenomycetes. Can. J. Bot. 1965, 43, 1097–1139. [Google Scholar]
- Stalpers, J.A. Identification of wood-inhabiting Aphyllophorales in pure culture. Study Mycol. 1978, 16, 1–248. [Google Scholar]
- Badalyan, S.M.; Sakeyan, C.Z. Morphological, physiological and growth characteristics of mycelium of several medicinal mushrooms (Aphyllophoromycetideae). Int. J. Med. Mushr. 2004, 6, 347–360. [Google Scholar]
- Granado, J.D.; Kertesz-Chaloupková, K.; Aebi, M.; Kües, U. Restriction-enzyme-mediated DNA integration in Coprinus cinereus. Mol. Gen. Genet. 1997, 256, 28–36. [Google Scholar]
- Zolan, M.E.; Pukkila, P.J. Inheritance of DNA methylation in Coprinus cinereus. Mol. Cell. Biol. 1986, 6, 195–200. [Google Scholar]
- Naumann, A.; Navarro-González, M.; Sanchez-Hernandez, O.; Hoegger, P.J; Kües, U. Correct identification of wood-inhabiting fungi by ITS analysis. Curr. Trends Biotechnol. Pharm. 2007, 1, 41–61. [Google Scholar]
- Ewing, B.; Hillier, L.; Wendl, M.C.; Green, P. Base-calling of automated sequencer traces using phred. I. Accuracy assessment. Genome Res. 1998, 8, 175–185. [Google Scholar]
- Staden, R.; Beal, K.F.; Bonfield, J.K. The Staden package, 1998. Meth. Mol. Biol. 2000, 132, 115–130. [Google Scholar]
- Tamura, K.; Dudley, J.; Nei, M.; Kumar, S. MEGA4: Molecular evolutionary genetic analysis (MEGA) software version 4.0. Mol. Biol. Evol. 2007, 24, 1596–1599. [Google Scholar]
- Nobles, M. A rapid test for extracellular oxidase in cultures of wood-inhabiting Hymenomycetes. Can. J. Bot. 1958, 36, 91–99. [Google Scholar]
- Thorn, R.G. The use of cellulose azure agar as a crude assay of both cellulolytic and ligninolytic abilities of wood inhabiting fungi. Proc. Jpn. Acad. Ser. B 1993, 69, 29–34. [Google Scholar]
- Soponsathien, S. Some characteristics of ammonia fungi. J. Gen. Appl. Microbiol. 1998, 44, 337–345. [Google Scholar]
- Matsumura, E.; Yamamoto, E.; Numata, A.; Kawano, T.; Shin, T.; Murao, S. Structures of the laccase-catalyzed oxidation products of hydroxybenzoic acids in the presence of ABTS (2,2′-azino-di-(3-ethylbenzothiazoline-6-sulfonic acid)). Agric. Biol. Chem. 1986, 50, 1355–1357. [Google Scholar]
- Uljé, C.B. Coprinus - Studies in Coprinus—Keys to Subsections and Species in Coprinus. Available online: http://www.grzyby.pl/coprinus-site-Kees-Uljee/species/Coprinus.htm (accessed on 19 February 2011).
- Fraiture, A.; Vanholen, B. Coprinus strossmayeri et ses synonymes. Bull. Soc. mycol. Fr. 2000, 116, 1–18. [Google Scholar]
- Uljé, C.B.; Noordeloos, M.E. Type studies in Coprinus subsect. Alachuani. Proc. Konin. Nederl. Akad. Wetenschappen - Biol. Chem. Geolog. Phys. Med. Sci. 1996, 99, 105–124. [Google Scholar]
- Uljé, C.B.; Noordeloos, M.E. Studies in Coprinus IV. Coprinus section Coprinus. Subdivision and revision of subsection Alachuani. Persoonia 1997, 16, 265–333. [Google Scholar]
- Kuo, M. Coprinus quadrifidus, Available online: http://www.mushroomexpert.com/coprinus_quadrifidus.html (accessed on 19 February 2011).
- Yamato, M.; Yagame, T.; Suzuki, A.; Iwase, K. Isolation and identification of mycorrhizal fungi associating with an achlorophyllous plant Epipogium roseum (Orchidaceae). Mycoscience 2005, 46, 73–77. [Google Scholar]
- Pitkaranta, M.; Meklin, T.; Hyvarinen, A.; Paulin, L.; Auvinen, P.; Nevalainen, A.; Rintala, H. Analysis of indoor dust fungal flora by rDNA sequence analysis, quantitative PCR and culture. Appl. Environ. Microbiol. 2007, 74, 233–244. [Google Scholar]
- Clémençon, H. Cytology and Plectology of the Hymenomycetes; J. Cramer: Berlin/Stuttgart, Germany, 2004. [Google Scholar]
- Hongo, T.; Yokoyama, K. Materials for the fungus flora of Japan. Trans. Mycol. Soc. Japan 1976, 17, 140–143. [Google Scholar]
- Immerzeel, G. Coprinus strossmayeri: nieuw voor Nederland. Coolia 1997, 40, 39–43. [Google Scholar]
- Keleş, A.; Demirel, K. Macrofungal diversity of Erzincan province (Turkey). Int. J. Bot. 2010, 6, 383–393. [Google Scholar]
- Enderle, M.; Bender, H. Studien zur Gattung Coprinus (Pers.: Fr.) S.F. Gray in der Bundesrepublik Deutschland. Z. Mykol. 1990, 56, 19–50. [Google Scholar]
- Mornand, J. Coprinus populicola Mornand, nov. sp. Doc. Mycol. 1998, 28, 69–72. [Google Scholar]
- Oliver, P.J.; Perkins, J.; Jellison, J. Effect of fungal pretreatment of wood on successional decay by several inky cap mushroom species. Int. Biodet. Biodeg. 2010, 7, 646–651. [Google Scholar]
- Leonowicz, A.; Matuszewska, A.; Luterek, J.; Ziegenhagen, D.; Wojtas-Wasilewska, M.; Oho, N.S.; Hofrichter, M.; Rogalski, J. Biodegradation of lignin by white rot fungi. Fungal Genet. Biol. 1999, 27, 175–185. [Google Scholar]
- Hoegger, P.J.; Kilaru, S.; James, T.Y.; Thacker, J.R.; Kües, U. Phylogenetic comparison and classification of laccase and related multicopper oxidase protein sequences. FEBS J. 2006, 273, 2308–2326. [Google Scholar]
- Merrill, W.; Cowling, E.B. Role of nitrogen in wood deterioration. 4. Relationship of natural variation in nitrogen content of wood to its susceptibility to decay. Phytopathol. 1966, 56, 1324–1325. [Google Scholar]
- Levi, M.P.; Cowling, E.B. Role of nitrogen in wood deterioration. 7. Physiological adaptation of wood-destroying and other fungi to substrates deficient in nitrogen. Phytopathol. 1969, 59, 460–468. [Google Scholar]
- Anh, D.H.; Ullrich, R.; Benndorf, D.; Svatos, A.; Muck, A.; Hofrichter, M. The coprophilous mushroom Coprinus radians secretes a haloperoxidase that catalyzes aromatic peroxygenation. Appl. Env. Microbiol. 2007, 73, 5477–5485. [Google Scholar]
- Sagara, N. Ammonia fungia chemoecological grouping of terrestrial fungi. Cont. Biol. Lab. Kyoto Univ. 1975, 24, 205–276. [Google Scholar]
© 2011 by the authors; licensee MDPI, Basel, Switzerland. This article is an open access article distributed under the terms and conditions of the Creative Commons Attribution license (http://creativecommons.org/Licenses/by/3.0/).
Share and Cite
Badalyan, S.M.; Szafranski, K.; Hoegger, P.J.; Navarro-González, M.; Majcherczyk, A.; Kües, U. New Armenian Wood-Associated Coprinoid Mushrooms: Coprinopsis strossmayeri and Coprinellus aff. radians. Diversity 2011, 3, 136-154. https://doi.org/10.3390/d3010136
Badalyan SM, Szafranski K, Hoegger PJ, Navarro-González M, Majcherczyk A, Kües U. New Armenian Wood-Associated Coprinoid Mushrooms: Coprinopsis strossmayeri and Coprinellus aff. radians. Diversity. 2011; 3(1):136-154. https://doi.org/10.3390/d3010136
Chicago/Turabian StyleBadalyan, Susanna M., Karol Szafranski, Patrik J. Hoegger, Monica Navarro-González, Andrzej Majcherczyk, and Ursula Kües. 2011. "New Armenian Wood-Associated Coprinoid Mushrooms: Coprinopsis strossmayeri and Coprinellus aff. radians" Diversity 3, no. 1: 136-154. https://doi.org/10.3390/d3010136
APA StyleBadalyan, S. M., Szafranski, K., Hoegger, P. J., Navarro-González, M., Majcherczyk, A., & Kües, U. (2011). New Armenian Wood-Associated Coprinoid Mushrooms: Coprinopsis strossmayeri and Coprinellus aff. radians. Diversity, 3(1), 136-154. https://doi.org/10.3390/d3010136



